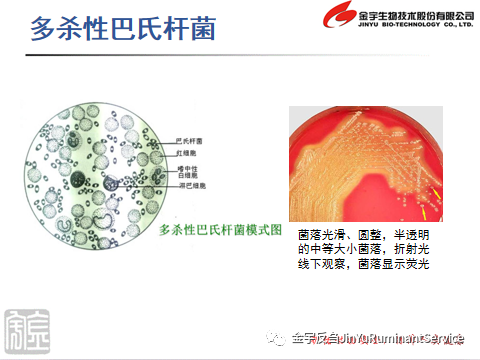

牛多杀性巴氏杆菌病的防控
牛出血性败血症是由多杀性巴氏杆菌引起的以败血症和组织器官的出血性炎症为特征的传染病,简称牛出败。它可以感染猪、马、羊、家禽、家兔及多种野生动物,也称为猪肺疫,牛出败及禽霍乱等,在学术上统称为多杀性巴氏杆菌病。由于多杀性巴氏杆菌的血清型不同,其生物学特性差异很大,主要表现在毒力和流行病学方面,重点介绍一下在牛上面常见的荚膜B型、荚膜A型巴氏杆菌及溶血性曼氏杆菌。

一、流行病学:
牛巴氏杆菌病一般多散发,无明显季节性;牛群发生巴氏杆菌病时,往往查不出传染源,一般认为在发病前已经带菌。牛多在春、夏劳役耕作和气候骤变季节多见或在寒冷、闷热、潮湿、拥挤、圈舍通风不良、阴雨连绵、营养缺乏、饲料突变、过度疲劳、长途运输、寄生虫感染等应激因素的作用下机体抵抗力降低时,病菌趁虚侵入体内,引起发病。
患病动物通过排泄物、分泌物不断排出有毒力的病菌,污染饲料、饮水、用具和外界环境,经消化道传染给健康动物;也可由咳嗽、喷嚏排出病菌,通过飞沫经呼吸道传播本病;吸血昆虫作为媒介也可传播本病;也可能原来肺已存在病菌,一旦机体内环境改变,抵抗力减弱,导致巴氏杆菌大量繁殖而发病;或可经皮肤、黏膜的伤口发生感染。
不同畜禽之间一般不易互相传染本病,但在个别情况下猪巴氏杆菌可传染给水牛。黄牛和水牛之间可亦互相传染本病,而禽和兽之间的相互传染则颇为少见,但水牛、牦牛有时可呈地方性流行。
二、发病机理:
一般认为牛在发病前已经带菌,多杀性巴氏杆菌可大量寄生在牛的上呼吸道和消化道黏膜上,各种诱因使牛的机体抵抗力降低时,病原菌趁虚侵入体内,经淋巴液而入血液发生内源性感染。此外,也可经呼吸道、消化道以及损伤的皮肤和黏膜发生外源性感染。病原侵入机体并繁殖的能力同菌体的荚膜有很大关系,高毒力菌株能够在体内存活和繁殖从而产生大量内毒素,引起一系列的病理学过程。

三、临床症状:
1、荚膜B型巴氏杆菌引起的牛出血性败血症
牛出败潜伏期一般2~5天,临床分为三种类型。
败血型:病初体温升高至41~42℃,精神沉郁,食欲废绝,反刍停止,呼吸困难,黏膜发绀,鼻流带血泡沫,腹痛腹泻,粪便带血,一般于24小时内虚脱而死。
浮肿型:病牛头颈和胸前水肿,肿胀、热痛,皮肤和黏膜发绀,眼红肿、流泪,舌咽高度肿胀,吞咽和呼吸困难,常因窒息而死。病程12~36小时。
肺炎型:主要表现纤维素性胸膜肺炎症状,病牛呼吸困难,有痛性干咳,鼻流无色或带血泡沫,有的病畜极度呼吸困难,有血性下痢,多衰竭而死,病程3~7天。

2、荚膜A型巴氏杆菌和溶血性曼氏杆菌引起的牛运输热和犊牛肺炎
混群引发的运输热(纤维素性肺炎)
运输热的发病机制是复杂的和多因素的。饲养管理、应激、多种传染源、肺的局部防卫机制和免疫应答均参与疾病过程,但严重临床症状和死亡的最终原因通常为溶血性曼氏杆菌和A型多杀性巴氏杆菌引起的纤维素性肺炎,因此,常用肺炎型巴氏杆菌病代替运输热。该病2003年发现于英国,2006年已传入我国。目前该病原已经扩散到我国的大部分地区,在牛群中引起严重的呼吸道病(BRD),危害极大,而在偏远地区,该病的发生依然严重,近几年继续由内陆向偏远地区或偏远地区之间蔓延。该病不分品种,奶牛和肉牛均可发生,运输热的发生以肉牛最为频繁和严重。
长途运输的应激加之混群的影响,使牛在运输途中开始发病,主要表现为犊牛群频繁发生以急性死亡和纤维素性化脓性肺炎为主要症状。体温41℃以上、咳嗽、腹泻、气喘、呼吸困难,急性病例6~24小时死亡,剖检可见内脏器官充血并有出血点,亚急性和慢性病例的肺组织广泛淤血、纤维素性渗出和粘连,肺组织散在大小不一的脓肿结节,表现纤维素性化脓性肺炎,用各种抗菌素治疗效果不明显,发病牛均预后不良。

四、诊断:
根据流行特点、临床症状和病理变化可对牛巴氏杆菌病作出初步诊断。其病理诊断要点为:体温40~42℃,呼吸困难,肌肉震颤,腹痛,下痢恶臭,或喉部肿胀,流涎,或肺部叩诊疼痛,流鼻液,便秘,下痢。确诊有赖于实验室细菌学检查,病料涂片可见两极浓染的杆菌,也可进行生化特性和PCR鉴定。
五、综合防控:
①免疫接种:可在运输前1~3周提前免疫接种全菌体灭活疫苗,有较好的效果,但是需要政府、企业、养殖户共同配合,加强进行宣传、技术培训和强制免疫。
②避免混群运输:特别是不同牛源的牛只从交易市场买入后直接进行长途运输,发病更严重,最好是从一个牛场经过检疫后,在进行抗应激处理的情况下再进行运输。
③在牛场有发生此病的情况下,不要引进未进行过免疫的健康牛群,否则会直接导致犊牛肺炎发生,发病率一般能达到10%~30%。
④加强饲养管理,冬季要注意防寒保暖,多增加营养和含维生素高的青绿饲料,夏季应注意通风降温,增加饮水次数和运动。对饲养环境及饲养用具进行定期消毒。
⑤病牛应单独隔离治疗,应尽量减少应激反应,提高机体的抵抗力。
重点在于如何解除免疫抑制,治疗过程中大量使用糖皮质激素及其他免疫抑制剂,以及抗菌药物的滥用会对牛只正常菌群产生破坏和耐药性,使得药物治疗的效果越来越差,可供选择药物的空间也越来越小,这就给药物防治带来很大的困难。
因此使用有效的疫苗来预防巴氏杆菌病越来越受到重视并被广泛的采用。
上一篇:传染性胃肠炎、病毒性腹泻治疗方案
最新更新
推荐阅读
关注我们

公司简介
养殖技术
产品展示
新闻资讯
市场行情
生活探索
执业兽医
联系我们
网站首页

